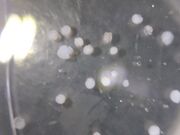

Uploads by Rachel Gill
From OpenWetWare
Jump to navigationJump to search
This special page shows all uploaded files.
| Date | Name | Thumbnail | Size | Description |
|---|---|---|---|---|
| 17:41, 28 November 2018 | PVA clay 1 0006.jpg (file) |  |
1.16 MB | PVA/clay SEM 5 |
| 17:40, 28 November 2018 | PVA clay 1 0002.jpg (file) |  |
584 KB | PVA/clay SEM 4 |
| 17:39, 28 November 2018 | PVA clay 1 0001.jpg (file) |  |
451 KB | PVA/clay SEM 3 |
| 17:37, 28 November 2018 | PVA clay 1 0003.jpg (file) |  |
848 KB | PVA/clay SEM 2 |
| 17:36, 28 November 2018 | PVA clay 1 0005.jpg (file) |  |
1.04 MB | PVA/clay SEM |
| 17:34, 28 November 2018 | PVA 1 0002.jpg (file) |  |
876 KB | PVA SEM 2 |
| 17:33, 28 November 2018 | PVA 1 0001.jpg (file) |  |
431 KB | PVA SEM image. |
| 18:54, 26 October 2018 | 20181026 133144.jpg (file) | |
3.94 MB | composite particles of PVA and clay from 10/24 |
| 18:53, 26 October 2018 | 20181026 133134.jpg (file) |  |
3.28 MB | scale to measure partciles |
| 16:54, 26 October 2018 | 20181024 112426.jpg (file) |  |
3.7 MB | olive oil set up for clay composite particles |
| 13:22, 24 October 2018 | IMG 2269.jpg (file) |  |
113 KB | New set up for experimental design 10/17/18. |
| 11:41, 10 October 2018 | New tubing setup RG.jpg (file) |  |
3.73 MB | This image shows the new set-up that was created using the new tygon tubing to create composite beads for water treatment. |
| 15:28, 26 September 2018 | 20180926 111723.jpg (file) |  |
3.7 MB | Polymer beads forming in ethyl acetate. |
| 15:00, 26 September 2018 | Setup 9-26.jpg (file) |  |
1.52 MB | Syringe pump set up for dual pumps trail 1. |
| 19:18, 12 September 2018 | Fluorescence stnd curve RG.png (file) |  |
10 KB | Rhodimine fluorescence standard curve, intensity versus concentration. |
| 18:05, 12 September 2018 | Stnd curve of new MG conc RG.png (file) |  |
13 KB | New standard curve of peak absorbance at 617 nm vs concentration made with new Malachite green samples. |
| 18:00, 12 September 2018 | Stnd curve of MG abs and conc RG.png (file) |  |
19 KB | Standard curve of Malachite green peak absorbance at 617 nm versus the concentration of the solution. |
| 03:25, 12 September 2018 | Uv-vis absorbance of new malachite green solns RG.png (file) |  |
39 KB | New Malachite green samples were run in UV-vis to try to fit standard curve better. |
| 03:22, 12 September 2018 | Uv-vis absorance malachite green solns RG.png (file) |  |
41 KB | This is a graphical representation of the UV-vis absorbance of Malachite green standard solutions versus wavelength. |